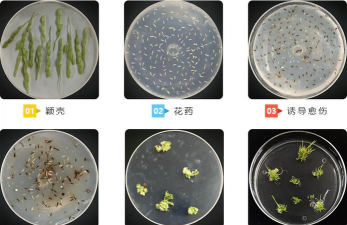
家庭养花用生根粉

下雪天在家养花好吗吗
下雪天在家养花是否合适,取决于具体的气候条件和花卉种类。以下是几种常见情况的分析:
1. 室内环境
- 优点:下雪天室内温度通常较为稳定,适合多数花卉生长。尤其是温度在 10°C 以上时,许多花卉可以正常生长。
- 注意事项:避免将花盆放在暖气附近,以免温度过高导致花卉脱水或生长过快。
2. 室外环境
- 优点:如果雪量不大,且温度适宜,下雪天可以给花卉提供自然的光照和湿度,有助于植物生长。
- 注意事项:避免在积雪过厚的地方种植,以免影响根系呼吸和排水。雪融化后应及时清理,防止积水。
3. 特殊花卉
- 多肉植物:喜欢干燥环境,雪天室内种植可能更合适。
- 观叶植物:如绿萝、龟背竹等,适合在室内环境下生长。
- 开花植物:如郁金香、风信子等,雪天可能会影响其开花周期,建议在室内或室内环境中种植。
4. 其他建议
- 保持通风:下雪天室内通风良好,有助于减少病虫害。
- 避免过度浇水:雪天土壤湿度较高,应避免频繁浇水,以免根部腐烂。
综上所述,下雪天在家养花是可行的,但需根据具体花卉种类和环境条件进行调整。如果条件允许,建议在室内种植,以确保花卉健康生长。
为什么吊兰长得很慢
吊兰生长缓慢可能由多种因素导致,以下是一些常见的原因及解决方法:吊兰喜欢明亮但不强烈的光照,如果生长环境过于阴暗,会导致光合作用不足,生长缓慢。解决方法:增加光照,建议放置在朝南或朝西的窗边,避免长时间处于阴暗处。吊兰不喜欢积水,但也不耐旱
· 2025-11-10

为什么有些植物不能水培
植物不能水培的原因主要与植物的生理需求、根系发育以及水培环境的限制有关。以下是常见的原因:植物的根系需要土壤中的有机质、微生物和养分来促进生长。水培环境中缺乏这些因素,可能导致根系发育不良,影响植物的吸收能力和整体生长。水培系统中,如果养分
· 2025-11-10

赞扬自己植树节养花的话
在植树节期间养花,不仅能够美化环境,还能提升生活质量。以下是一些可以用来赞扬自己植树节养花的表达方式:“植树节期间养花,让我更加热爱自然,感受到生命的美好与希望。”“在植树节里种下花草,不仅美化了环境,也让我更加重视环保和可持续发展。”“植
· 2025-11-10

花植物怎么种植方法
种植花植物需要根据不同的种类和环境条件来选择合适的方法。以下是一些常见的种植方法和建议:根据气候选择:不同花卉对温度、湿度、光照的要求不同,例如多肉植物适合干燥环境,而玫瑰则需要充足的阳光和良好排水。根据空间选择:阳台、窗台、庭院等不同空间
· 2025-11-10

桂花花朵怎么保存
桂花花朵的保存方法可以根据不同的用途和保存时间来选择。以下是几种常见的保存方式:方法:将桂花花朵放入保鲜袋或密封容器中,保持干燥和通风,避免阳光直射。注意事项:避免使用水或湿物,以免花朵腐烂。保存时间一般为1-2天。方法:将桂花花朵晾干后,
· 2025-11-10

什么是离体培养花药
离体培养花药是植物组织培养中的一种技术,主要用于花药(花粉管)的培养。花药是植物花中的雄性生殖器官,含有花粉粒,是植物繁殖的重要部分。离体培养花药是指将花药作为单个组织或细胞,在无菌、无毒的环境中进行培养,以获得新的植株或遗传材料。花药培养
· 2025-11-10
办公室养花用什么花盆
在办公室养花时,选择合适的花盆非常重要,既要考虑美观,又要兼顾植物的生长需求。以下是几种常见的花盆类型及适用场景:优点:轻便、价格低、透气性好,适合室内养护。适用场景:适合大多数室内植物,尤其是对排水要求不高的植物。注意事项:避免使用质量差
· 2025-11-10

多肉怎么分多头
分多头是多肉植物繁殖的一种常见方法,可以提高植株数量,同时保持植株的美观和健康。以下是分多头的常用方法:1. 选择健康的母株首先选择一个健康、无病虫害的母株,确保其生长旺盛,根系发达。2. 修剪老枝在生长季节(通常为春夏季)进行修剪,去除老
· 2025-11-10

菊花为什么要摘蕾
菊花在栽培过程中,摘蕾是一项重要的管理措施,其主要目的是为了提高菊花的品质和产量。以下是摘蕾的主要原因:菊花在生长过程中,花芽的形成与养分的分配密切相关。摘蕾可以减少养分的消耗,使养分更集中于花芽的发育,从而提高花的质量和花的大小。摘蕾可以
· 2025-11-10

房间放什么花最好看
在房间放置花卉,可以提升空间的美观度和空气质量。以下是一些适合放在房间的花卉建议,根据不同的环境和需求进行选择:绿萝:适应性强,适合室内养殖,能有效净化空气。吊兰:生长迅速,适合悬挂式摆放,适合小空间。仙人掌:耐旱,适合光线充足的地方,是室
· 2025-11-10





